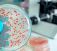

Shopping

Meno di 15 euro: è questo il prezzo dei blazer più cool

Katie Holmes, le sue ballerine chic sono il must del momento
DiLei

Kate Middleton, la nuova casa colpita dal nubifragio: trasloco a rischio

Ancora guai per Meghan: "mollata" dopo soli 4 mesi
Magazine

Lino Guanciale ha fatto di tutto per quel lavoro, ha distrutto un legame

Addio Mauro Di Francesco, la causa della morte dell'attore iconico
Offerte della settimana

Set cavatappi
Elettrico e portatile, per bottiglie di vino InnovaGoods
-43%
Scopri

Set Wok + Grill
Set padella wok e bistecchiera in alluminio Tognana
-53%
Scopri

Pc
Ricondizionato, 256gb e schermo da 15.6" Dell
-%
263€
Scopri
DiLei Girlz

Jenna Ortega in top corazza è seduzione pura

Jenna Ortega, la sua giacca di pelle è già un'ossessione

Ho visto mia madre baciare un uomo che non era mio padre

Il bastone smart che aiuta i ciechi a sentirsi più sicuri e autonomi
QF Green

In Italia investimento da 50 milioni per gas pulito
Batteri nelle piante italiane: li stanno studiando adesso

Sostenibilità, scambio intergenerazionale, uso consapevole della tecnologia. La giusta traiettoria

Eccellenze italiane: visione e innovazione nel mondo dei vetri
DiLei Home&Living

Casa, atmosfere d'autunno

Angolo cinema in casa: idee per serate autunnali perfette
QuiFinanza

Stretta all'evasione: movimenti controllati in tutta Europa
































































 0
0
 0
0
 0
0
 0
0
 0
0
 0
0
 0
0
 0
0
 0
0
 0
0
 0
0
 0
0
 0
0
 0
0






































































































